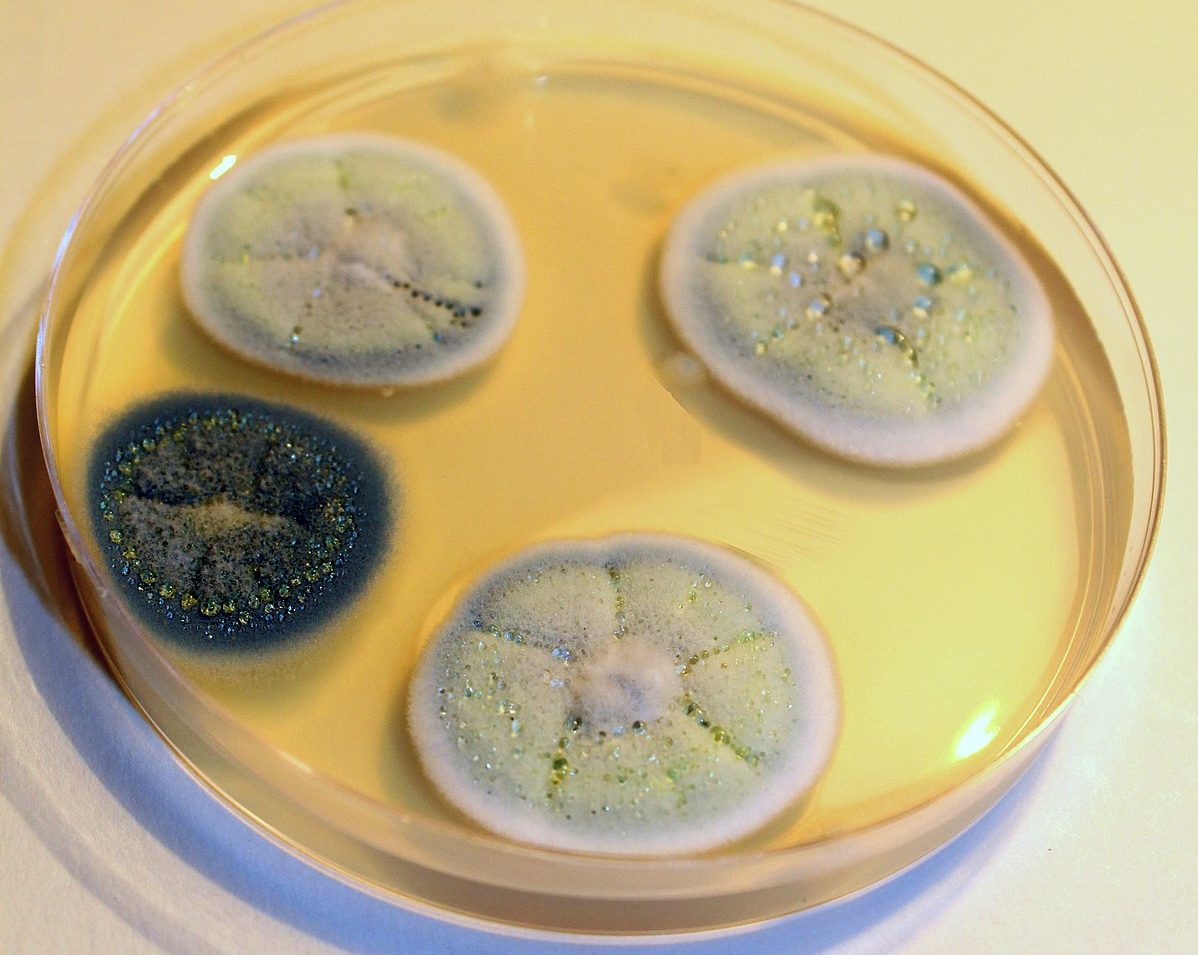
페니실리움

곰팡이와 균류는 인류 출현 훨씬 이전부터 지구상에 존재해 왔습니다. 이들은 매우 회복력이 강한 유기체로, 자연 생태계의 정상적인 기능에 필수적입니다. 곰팡이는 치명적일 수 있어 인간에게 위험합니다. 하지만 동시에 인류에게 엄청난 혜택을 가져다주기도 합니다. 어떤 종들은 의학에서 항생제를 생산하는 데 사용되어 사람들을 질병으로부터 구합니다.
곰팡이 균류의 종류와 사진을 통한 설명
곰팡이 균류는 미세균류(micromycetes)라고 합니다. 미세한 구조를 가지고 있으며, 매우 얇고 여러 줄로 이루어진 균사체로 이루어져 있습니다. 이 균사체는 분지되어 있고, 격막이 거의 없으며, 다핵 균사체의 기부를 형성합니다. 사진에서 균사체의 구조를 자세히 볼 수 있습니다.
몰드의 특징은 다음과 같습니다.
- 균사체는 식물체의 기본이며, 실처럼 갈라진 균사입니다.
- 균사체의 크기가 크다.
- 균사체는 효모와 달리 세포로 나뉩니다.
- 번식에는 무성생식, 유성생식, 무성생식의 세 가지 방법이 있습니다.
곰팡이에는 여러 가지 분류가 있습니다. 가장 일반적으로 사용되는 분류는 색깔에 따른 분류(버섯은 흰색, 노란색, 검은색, 녹색, 갈색 또는 빨간색일 수 있음)와 세포 수에 따른 분류입니다.
다음 내용에 관심이 있으실 수도 있습니다.곰팡이는 세포 수에 따라 접합균류(zygomycetes)와 자낭균류(ascomycetes)의 두 가지 유형으로 나뉩니다. 접합균류는 단세포 균류의 작은 그룹입니다. 자낭균류는 다세포 균류입니다.
진균학자들은 곰팡이를 4가지 속으로 구분합니다.
- 아스페르길루스.
- 보트리티스.
- 페니실리움.
- 히포미세스.
아스페르길루스속(Aspergillus)은 수백 종으로 이루어져 있습니다. 균사체에는 고등 균류의 특징인 격막이 있습니다. 처음에는 흰색이지만, 성숙하면서 다양한 색조를 띠게 됩니다. 아스페르길루스속은 무성생식하지만, 일부 고등 균류는 유성생식을 할 수 있습니다.
많은 종의 아스페르길루스(Aspergillus)는 인체 건강에 해롭습니다. 심각한 질병을 유발할 수 있으며, 다양한 종이 식품 산업과 의학 분야에서 활발하게 사용되고 있습니다.
다음 내용에 관심이 있으실 수도 있습니다.보트리티스는 흔히 회색곰팡이로 알려져 있습니다. 균사체는 조밀하고 무색의 군체를 형성하며, 밀도가 높아 잿빛을 띱니다. 보트리티스균은 토양과 식물 잔해에 서식하는 단세포 균류입니다.
균사는 육안으로 확인할 수 있습니다. 이 속(屬)의 종은 변이가 매우 심하여 매우 다양한 형태를 보일 수 있습니다. 보트리티스(Botrytis) 종은 와인 제조에 없어서는 안 될 존재이며, 인간에게 특별한 위험을 초래하지 않습니다. 보트리티스 종은 과기생성 곰팡이의 영향을 받을 수 있습니다.
푸른곰팡이(Penicillium)는 귀한 곰팡이로 여겨집니다. 전통 의학뿐만 아니라 치즈와 소시지 생산에도 널리 사용됩니다. 푸른곰팡이속(Penicillium)에는 네 가지 종 그룹이 있습니다.
- 벨벳 같은;
- 펠트;
- 술이 달린;
- 코레미아가 있는 종.
페니실리움속(Penicillium)에 속하는 종들은 토양, 물, 공기에 서식합니다. 많은 종들이 식물과 먹이를 선호합니다. 곰팡이의 색깔은 종에 따라 다릅니다. 가장 흔한 것은 흰색, 노란색, 주황색 또는 갈색입니다. 빨간색과 검은색은 덜 흔합니다.
히포미세스 락티페러스(Hypomyces lactiferous)는 식용 곰팡이의 일종입니다. 이 곰팡이 속은 russula와 lactarius 같은 식용 버섯에서 자랍니다.

처음에는 곰팡이가 얇고 밝은 붉은색이나 밝은 주황색 막으로 나타납니다. 이 막은 나중에 돋보기로 보면 보이는 플라스크 모양의 자낭각으로 발전합니다.
히포미세스 락티플로라(Hypomyces lactiflora)는 별미로 여겨집니다. 버섯 채취인들은 삶은 바닷가재를 연상시키는 색깔과 해산물에 버금가는 냄새와 맛을 지닌 이 버섯을 "버섯 바닷가재"라고 부릅니다. 버섯 바닷가재는 단순히 먹는 것이 아니라 사냥하기도 합니다. 이 종은 인간의 생명이나 건강에 전혀 위협이 되지 않습니다.
인간의 곰팡이 사용
곰팡이는 식품 생산부터 제약 제조까지 다양한 산업 분야에서 널리 사용됩니다. 가장 흔히 사용되는 곰팡이 종류는 다음과 같습니다.
- Aspergillus niger 균주는 구연산을 생산하는 데 사용됩니다.
- Botrytis속의 균주는 와인 제조와 기타 알코올성 음료 제조에 적극적으로 사용됩니다.

포도 열매의 Botrytis cinerea - 일부 고귀한 곰팡이는 특별한 종류의 치즈(로크포르, 카망베르)와 건조 숙성 소시지를 만드는 데 사용됩니다.
- 페니실리움속(Penicillium)에 속하는 세균들은 페니실린 계열 약물의 주요 성분입니다. 이 약물들은 항생 및 살균 효과를 가지고 있습니다. 페니실린 계열 약물은 전통 의학에서 널리 사용됩니다.
곰팡이의 해로움
곰팡이는 그 효능에도 불구하고 심각한 해를 끼칠 수 있습니다. 그중에서도 아스페르길루스속(Aspergillus) 곰팡이가 가장 위험한 것으로 여겨집니다. 이 곰팡이는 사람과 동물을 감염시킬 수 있습니다. 가장 흔한 증상으로는 피부 병변, 외이도 감염, 알레르기 반응이 있습니다. 균종(Mycetoma)이라는 심각한 질환 또한 이 속 곰팡이에 의해 발생합니다.
Botrytis속은 정원 해충이라고 해도 과언이 아니다.
이 속의 대표균은 다음 식물에 많은 수의 곰팡이 질병을 유발합니다.
- 딸기;
- 포도;
- 양파;
- 일부 뿌리채소
- 감귤류;
- 가지과 식물
- 콩;
- 엷은 황갈색;
- 샐러드;
- 완두콩.
사람에게는 곰팡이 포자가 알레르기를 유발합니다. 때로는 곰팡이 포자가 호흡기 질환에 걸리기 쉬운 사람에게 폐 질환을 유발하기도 합니다.
재배 조건
곰팡이는 매우 흔합니다. 지구상 거의 모든 곳에서 자라며 거대한 군체를 형성합니다. 곰팡이는 공기, 토양, 물에서 살 수 있으며, 음식과 식물에 서식합니다.
군체의 목표는 모든 영양분을 흡수하는 것입니다. 군체의 먹이원이 고갈되면 활발한 포자 형성이 시작됩니다. 성숙한 포자는 영양분이 풍부한 새로운 장소로 퍼지는 반면, 오래된 균사체는 죽은 곳에 남습니다.

곰팡이는 주변 환경에 전혀 구애받지 않고 어떤 조건에서도 잘 자랍니다. 하지만 곰팡이가 번성하고 발달하기에 가장 유리한 조건은 다음과 같습니다.
- 탄수화물이 풍부함.
- 고온.
- 공기 습도가 증가했습니다.
곰팡이는 전분이 풍부한 기질에서 잘 자랍니다. 일부 과학자들은 곰팡이가 밝은 햇빛에서는 잘 자라지 않는다고 주장합니다. 이는 전적으로 사실이 아닙니다. 곰팡이는 습도가 높은 곳에서 잘 자라며, 직사광선은 습도를 건조하게 만듭니다. 따라서 곰팡이는 습도가 높은 곳에서는 잘 자라지 않습니다. 하지만 습도가 높은 곳에서는 밝은 빛이나 반그늘이 모두 문제가 되지 않습니다.
다음 내용에 관심이 있으실 수도 있습니다.자주 묻는 질문에 대한 답변
이 친숙한 곰팡이는 현재 과학적 논쟁의 대상입니다. 사람들은 곰팡이의 새로운 용도와 효능을 끊임없이 찾고 있으며, 수많은 질병의 원인으로 지목하고 곰팡이에 기적적인 약효가 있다고 주장합니다. 아래는 곰팡이에 대해 가장 자주 묻는 질문에 대한 답변입니다.
곰팡이 종은 매우 다양합니다. 이러한 곰팡이가 인간에게 주는 이점은 헤아릴 수 없을 만큼 큽니다. 그러나 일부 종은 인간에게 심각한 위험을 초래합니다.

느타리버섯은 사람에게 어떤 이점과 해로움이 있나요? (+27장 사진)
소금에 절인 버섯에 곰팡이가 생기면 어떻게 해야 하나요? (+11장 사진)
관형으로 간주되는 버섯은 무엇이며 그 설명은 다음과 같습니다(+39개 사진)
2021년 모스크바 지역에서는 언제, 어디에서 꿀버섯 따기를 시작할 수 있나요?